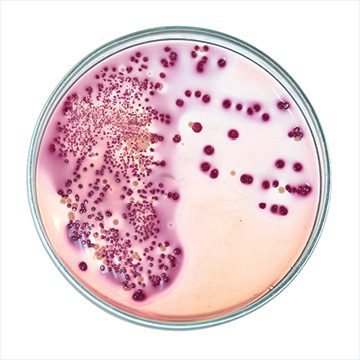
Food poisoning effects, recovery and healing

John Arts
I am John Arts, founder of Abundant Health.

David Coory
To be in my 80th year and feeling back to 100%

Shaun Holt
Aging and the Greek Island lifestyle.

Keith Michael
The science of delayed food poisoning.
Megan Amrein
The digestive system is the foundation of our health.

David Coory
I'm grateful to be alive.

John Arts
Understanding cholesetrol, diet and supplements.

Shaun Holt
Understanding the interaction risk.

Health House
How we prevent cross-contamination.

David Coory
Why we've introduced our new multi-mineral-vitamin.

Shaun Holt
There are various types of medical cannabis avalable.

Megan Amrein
Facts that can help manage histamine levels.